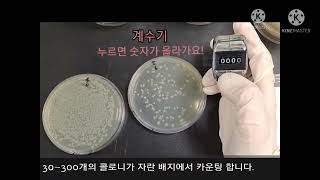

Bacteria enumeration: the standard plate count method video
Online izle ve mp4 mp3 formatlarinda yukle

Videonun muddeti: 0:26
Bacteria enumeration: the standard plate count method videosu mp4 ve mp3 yuklemek ucun hazirdir
Diqqet! Siz Mp4 yukle ve ya Mp3 yukle duymesine basdiqdan sonra eger sistem sizi reklam sehifesine atarsa o zaman derhal geri qayidib emeliyyati tekrar edin ve faylin yuklemek ucun hazir olmasini gozleyin
Videodan Mp4 Yukle
Videodan Mp3 Yukle-1
Videodan Mp3 Yukle-2
Oxshar Axtarishlar
 Standard plate count
Standard plate count Bacteria enumeration: the standard plate count method
Bacteria enumeration: the standard plate count method Serial Dilution and Plate Counts
Serial Dilution and Plate Counts Total Plate Count (Total Aerobic Bacterial Count)_A Complete Procedure (BAM, Ch-3)
Total Plate Count (Total Aerobic Bacterial Count)_A Complete Procedure (BAM, Ch-3) Lab 6-1: Standard Plate Count Technique
Lab 6-1: Standard Plate Count Technique Standard plate count method
Standard plate count method Standard Plate Count of Milk Bacteria Lab
Standard Plate Count of Milk Bacteria Lab Bacterial Growth Measurement: Direct and Indirect Methods Explained
Bacterial Growth Measurement: Direct and Indirect Methods Explained BIOL215L Lab 8 Serial Dilution and Enumeration
BIOL215L Lab 8 Serial Dilution and Enumeration
Video Mp4 Mp3Azwap.Biz
Azwap.Biz 2021-2023


 Standard plate count
Standard plate count Bacteria enumeration: the standard plate count method
Bacteria enumeration: the standard plate count method Serial Dilution and Plate Counts
Serial Dilution and Plate Counts Total Plate Count (Total Aerobic Bacterial Count)_A Complete Procedure (BAM, Ch-3)
Total Plate Count (Total Aerobic Bacterial Count)_A Complete Procedure (BAM, Ch-3) Lab 6-1: Standard Plate Count Technique
Lab 6-1: Standard Plate Count Technique Standard plate count method
Standard plate count method Standard Plate Count of Milk Bacteria Lab
Standard Plate Count of Milk Bacteria Lab Bacterial Growth Measurement: Direct and Indirect Methods Explained
Bacterial Growth Measurement: Direct and Indirect Methods Explained BIOL215L Lab 8 Serial Dilution and Enumeration
BIOL215L Lab 8 Serial Dilution and Enumeration